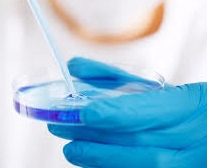

El Grupo ha incrementado un 27,5% su Ebitda, alcanzando los 3,9 millones de euros en 2015, frente a los 2,8 millones del ejercicio precedente. El resultado subió hasta 1,7 millones de euros, frente al 1,0 millones de euros un año antes. El beneficio por acción creció un 81,1% a 0,67 euros. Secuvita, la filial española de Vita 34, representa el 13,5% de la facturación del grupo alemán.
2015, año de adquisiciones
Las adquisiciones marcaron el ejercicio de 2015 junto con nuevos contratos de almacenamiento de células madre y la consolidación de las empresas adquiridas en años anteriores y ya integradas plenamente, como es el caso de la española Secuvita, referente en el mercado nacional y que comenzó su integración en el grupo alemán en 2010.
En 2015, Vita 34 ha adquirido Vivocell Biosolutions, el mayor banco privado de células madre de Austria, y StemCare, banco de conservación de células madre de cordón umbilical que opera en Dinamarca, Suecia, Turquía y Rumanía. Así, ha ampliado su presencia en los países escandinavos, con altas tasas de natalidad. También ha firmado un acuerdo de colaboración con Imunolita, el banco de células madre del Báltico, y continúa la colaboración con BioSave, su partner serbio.
Para Teresa Rebate, directora de Secuvita, “con estas operaciones, aumentamos nuestra capacidad de muestras crioconservadas, sumando la conservación de células de 145.000 bebés de toda Europa”. Vita 34 consolida su posición de liderazgo como uno de los bancos de sangre de cordón privados de Europa, realizando uno de cada dos trasplantes familiares con células madre de sangre de cordón conservada en bancos privados, con presencia en prácticamente todas las zonas geográficas europeas.
Nuevos segmentos de mercado
La introducción de nuevos servicios y productos ha sido clave en el crecimiento de Vita 34. La conservación de células madre a partir de diversos tejidos y su almacenamiento, así como el uso de terapias celulares, son dos de los nuevos servicios que Vita 34 ha añadido a su portfolio para fortalecer su posición. "trabaja activamente en sus propias actividades de investigación y desarrollo para ampliar el valor añadido mediante la introducción de nuevos productos para la producción farmacéutica y el apoyo a las terapias basadas en células madre", afirma el Dr. André Gerth, CEO del grupo alemán, que añade que "2016 se caracterizará por una mayor expansión, lo que incluye medidas para integrar las empresas adquiridas en el Grupo e iniciativas para aumentar la eficiencia.
Estamos convencidos de que estas inversiones futuras serán rentables y que nuestra estrategia de crecimiento es la adecuada para la consecución de resultados a largo plazo". De hecho, ya en el primer trimestre de 2016, ha hecho nuevos socios en Dubai y el Líbano y actualmente tiene previsto expandir su negocio a Albania.

Si (
Si ( No(
No(



















